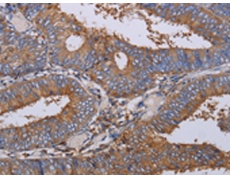
一抗

技術(shù)規(guī)格
Background:
The protein encoded by this gene is an adaptor protein which contains five LIM domains, or double zinc fingers. The protein is likely involved in integrin signaling through its LIM domain-mediated interaction with integrin-linked kinase, found in focal adhesion plaques. It is also thought to act as a bridge linking integrin-linked kinase to NCK adaptor protein 2, which is involved in growth factor receptor kinase signaling pathways. Its localization to the periphery of spreading cells also suggests that this protein may play a role in integrin-mediated cell adhesion or spreading. Several transcript variants encoding different isoforms have been found for this gene.
Applications:
ELISA, WB, IHC
Name of antibody:
LIMS1
Immunogen:
Fusion protein of human LIMS1
Full name:
LIM and senescent cell antigen-like domains 1
Synonyms:
PINCH; PINCH1; PINCH-1
SwissProt:
P48059
ELISA Recommended dilution:
2000-5000
IHC positive control:
Human colon cancer and human tonsil
IHC Recommend dilution:
50-200
WB Predicted band size:
37 kDa
WB Positive control:
Human kidney and mouse lung tissue
WB Recommended dilution:
500-2000


 購物車
購物車 幫助
幫助
 021-54845833/15800441009
021-54845833/15800441009